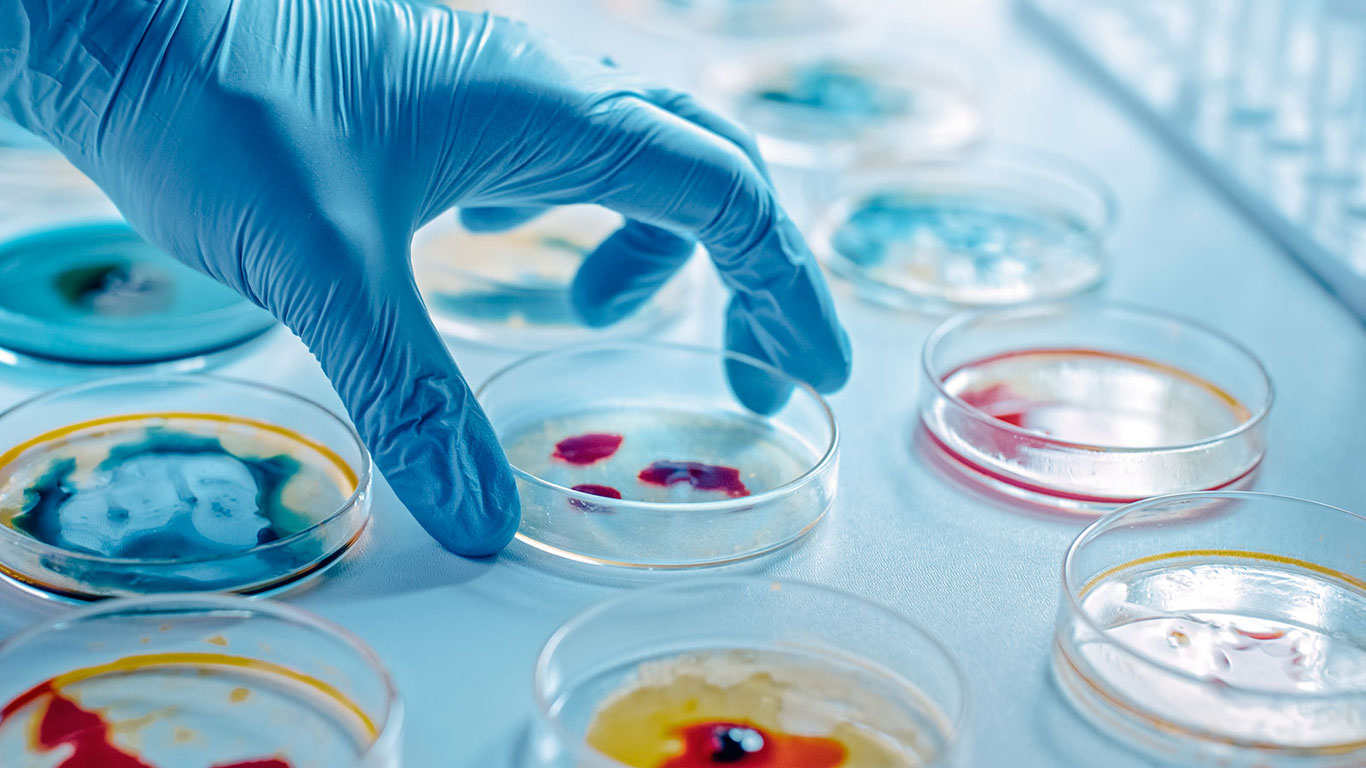
Олимлар янги микробларни кашф этди

Олимлар янги микробларни кашф этди
Улар иқлимни сезиларли даражада ўзгартириши мумкин.
Амазон ўрмонидаги торфзорларда топилган микроблар Ернинг глобал углерод балансига сезиларли таъсир кўрсатиши мумкин.
Олимлар мураккаб майда микроорганизмлар улкан экотизимларни шакллантириши ва сайёранинг келажакдаги иқлимига таъсир қилиши мумкинлигини аниқладилар. Тадқиқот Мисробиологй Спеструм журналида чоп этилди.
Олимлар Жанубий Американинг Перудаги Амазон тропик ўрмонларида кислород кам бўлган торфзорларда номаълум микроблар популяциясини аниқлади. Тадқиқот муаллифларининг фикрича, бу микроблар сайёранинг углерод айланишида икки томонлама роль ўйнайди. Бу жараён углеродни барқарорлаштириши ёки унинг карбонат ангидрид ва метан сифатида чиқарилишини бошлашида, албатта, муҳим ўринга эга.
Бу микроблар углерод оксидини истеъмол қилади ва уни энергияга айлантиради, шу билан бирга атроф-муҳитдаги углероднинг токциклигини камайтиради. Кимёвий бирикмаларни парчалаш орқали микроблар водород ва карбонат ангидрид ҳосил қилади, бошқа микроблар эса метан ишлаб чиқаришда фойдаланадилар.
Аммо ёғингарчилик, ҳарорат ва инсон фаолиятининг ўзгариши сабаб ерларнинг карбонат ангидрид ва метан каби иссиқхона газларини чиқишига олиб келади.
Олимларнинг фикрича, ер иқлим ўзгаришини қўзғатмаслиги учун уларни ҳимоя қилиш керак. Янги микроблар иқлим муаммоларини ҳал қилишда асосий элемент бўлиб, ҳатто энг кичик организмлар ҳам сайёрамизга катта таъсир кўрсатиши мумкинлигини кўрсатади.







